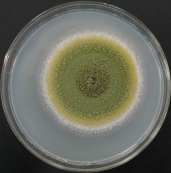

2022-06-25
小小益生菌,大大的能量
作者:韦德国际(中国)官方网站 畜牧兽医分院微生物研究所 田秋丰
益生菌大家并不陌生,但是大家知道吗,在畜禽养殖过程中,益生菌也能发挥很大的作用。
一、什么是益生菌?
联合国粮农组织(FAO)、世界卫生组织(WHO)以及国际益生菌和益生元科学协会(ISAPP)对益生菌给出了定义:益生菌是活的微生物,当摄入足够数量时,对宿主的健康产生益处。益生菌并不是什么稀奇物,每个人和动物肠道里都有。简单来说,胃肠道是重要的消化器官,里面既有导致生病的坏细菌,也有抑制有害菌、促进肠道蠕动、完善肠道屏障的好细菌,而益生菌就属于好细菌。

图片来源:百度图库
二、动物养殖中常见的益生菌种类
畜禽源益生菌菌种可分为 3 大类:乳酸菌类(如乳杆菌属、双歧杆菌属、肠球菌属、链球菌属);芽孢杆菌类(如凝结芽孢杆菌、枯草芽孢杆菌、短小芽孢杆菌、地衣芽孢杆菌);真菌类(如黑霉菌、啤酒酵母、产朊假丝酵母、酿酒酵母)。其中,乳酸菌是构成特定区域正常微生物菌群的重要成员,具有促进机体生长,参与宿主代谢活动,改善免疫能力等特性;而芽孢杆菌常来源于体外,具有抗逆性强、耐酸、耐胆盐、耐高温高压等特性,还能促进乳酸菌增殖。

图片分别为乳酸菌,芽孢杆菌和真菌
图片来源:韦德国际(中国)官方网站 畜牧兽医分院微生物研究所
三、益生菌的应用范围
1、促进营养物质吸收。益生菌繁殖过程中产生的代谢产物(淀粉酶、蛋白酶、脂肪酶等)可促进消化,同时,还可以分解维生素、生长因子、氨基酸等机体不能自行分解的物质。另外,还能够缓解肠道细胞凋亡,维持肠道形态结构完整。
2、提高免疫力,预防某些畜禽疾病发生。在肠道疾病方面,益生菌在预防和治疗急性胃肠炎、腹泻、便秘、炎症性肠病、过敏性综合征等方面具有较好的应用。在其他疾病方面。益生菌对机体肠道免疫有重要作用,可刺激机体淋巴细胞,增强机体体液免疫和细胞免疫,进而增强机体抗病力。有研究发现,益生菌对隐形奶牛乳房炎的治愈率可达 90%,对子宫内膜炎有一定治疗作用。
3、作为动物饲料应用。随着抗生素的禁用,绿色、安全、无毒新型饲料添加剂的开发已成为广大科技工作者的研究热点。我国对于微生物用于养殖行业中,也展开了广泛的研究。在2013版的饲料添加剂品种目录的基础上,2018年我国农业部拟将58种宠物(犬猫)专用的饲料添加剂增补进入其中,并对使用对象,作了规定。因此,在鸡鸭鹅等家禽、猪马牛羊等家畜、水产动物、宠物均可应用。
4、优化养殖环境。畜禽粪尿中有毒有害的气体、氮、磷、病原微生物等如得不到有效控制就会污染空气、土壤、水源。在饲料中添加益生菌能减少畜禽粪便中的恶臭物质、病原微生物、氮磷及重金属的排放,减少对环境造成的影响。
四、益生菌的未来
目前益生菌使用还正处于初始阶段,在提高畜禽生长性能、防治畜禽疾病的同时,也存在诸多问题亟需解决。如益生菌较易失活,活菌制剂在加工、运输和保存过程中容易失去活性;市场上益生菌相关产品较多且产品质量良莠不齐,对畜产品产生的安全性不明确;在生产上官方没有严格统一的检测标准。因此,仍需要继续对其进行不断地开发和利用,推动益生菌在畜禽业上的应用,进而推动养殖业的长足发展。
主办单位:韦德国际(中国)官方网站 备案序号:黑ICP备11000329号技术支持:韦德国际(中国)官方网站 农业遥感与信息研究所